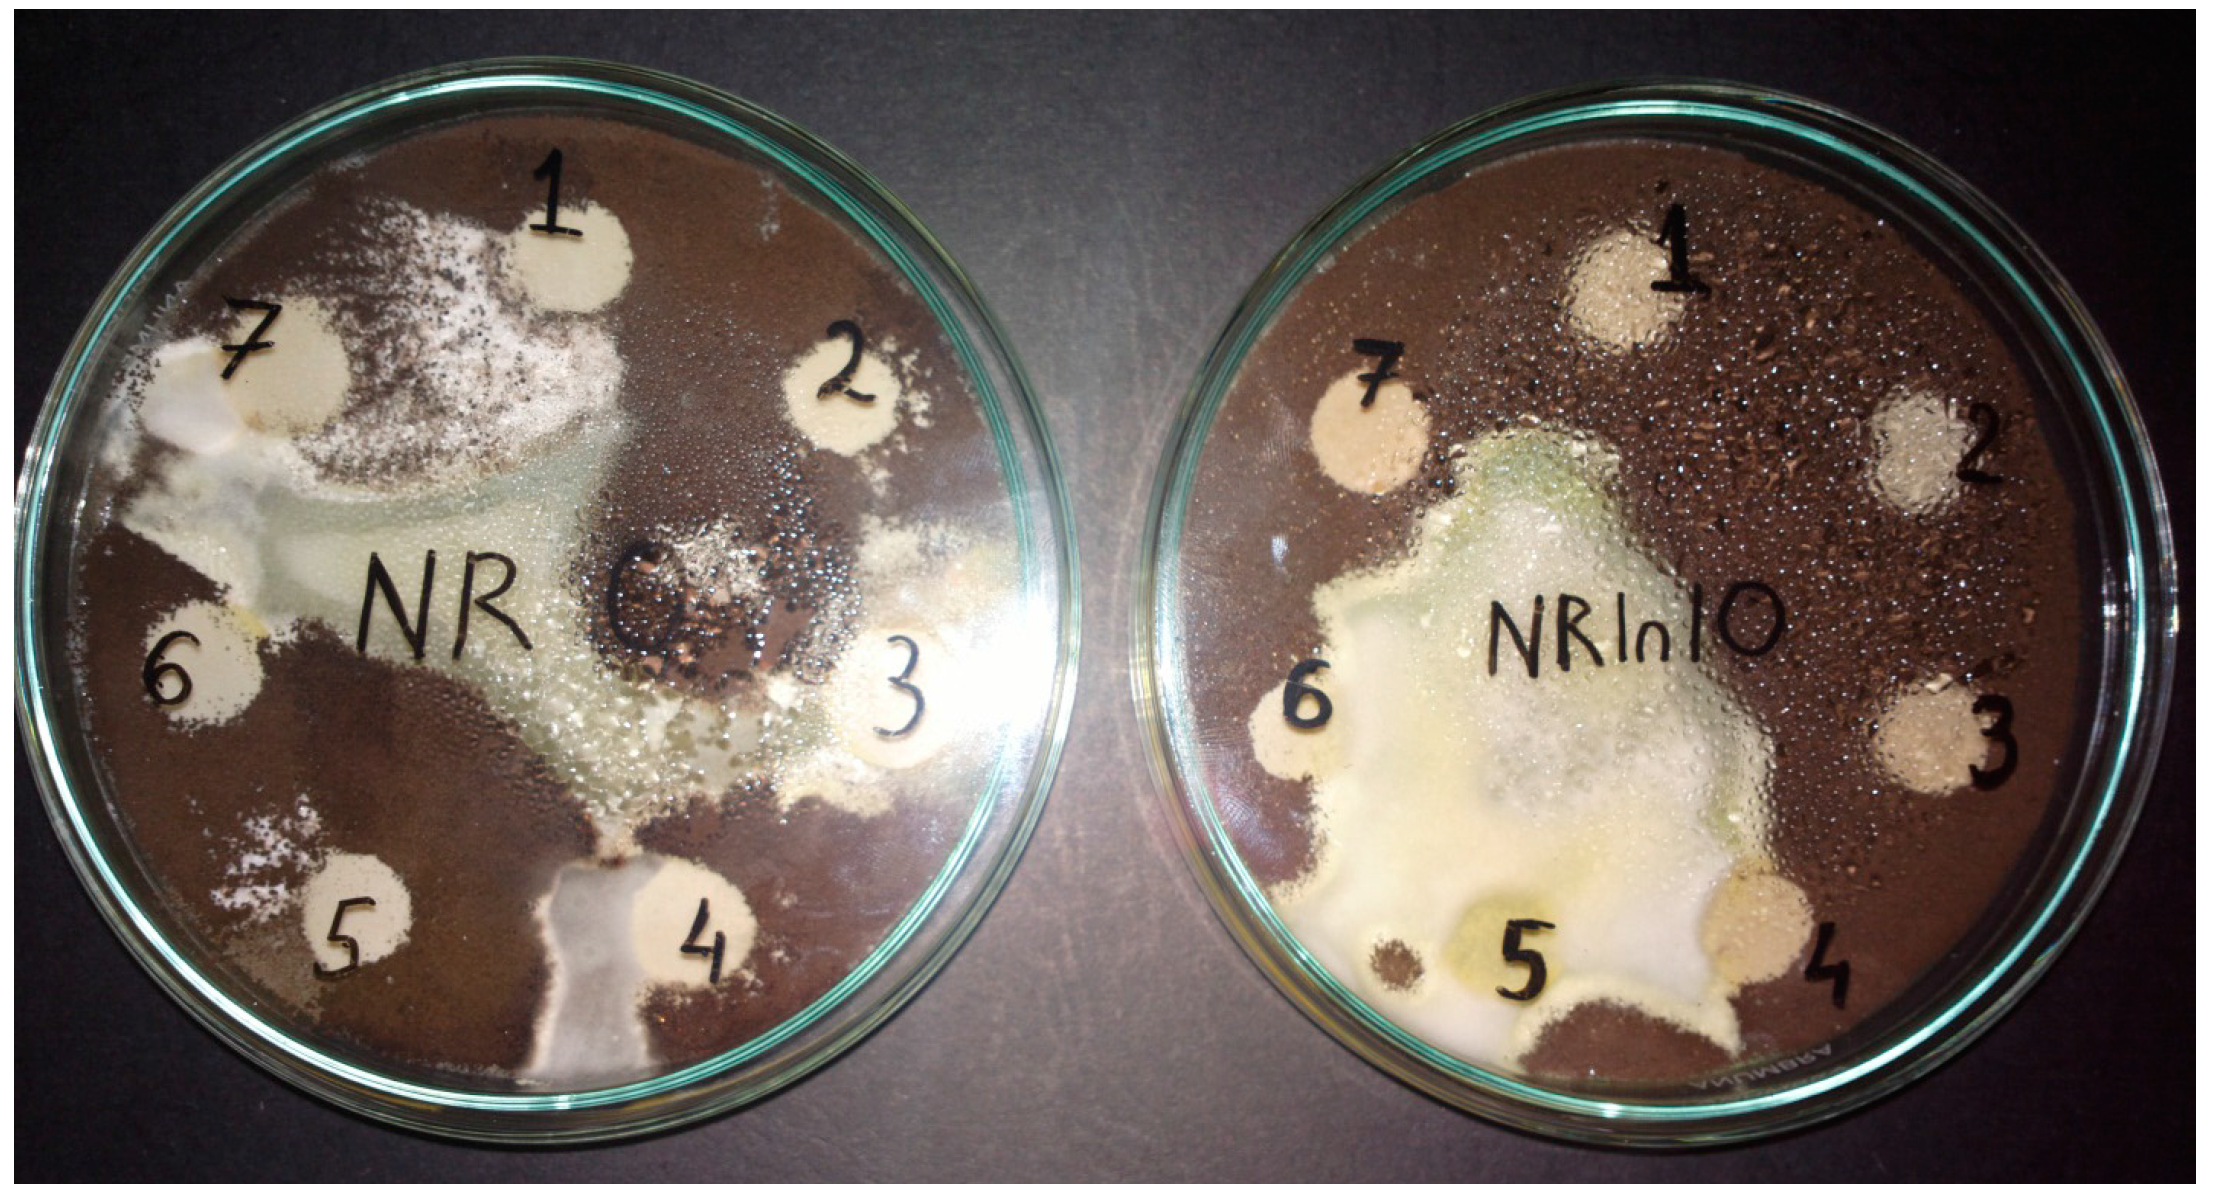
Materials 10 00787 g002

Development and Characterization of Polymer Eco-Composites Based on Natural Rubber Reinforced with Natural Fibers
Abstract
:1. Introduction
2. Experimental
2.1. Materials Used for Composites Preparation
2.2. Methods for Obtaining Elastomeric Composites
2.3. Sample Inoculation
2.4. Laboratory Tests
3. Results and Discussion
3.1. Mass Loss after Biodegradability Tests
3.2. Gel Fraction and Cross-Link Density of Blends
3.3. Rubber–Fiber Interactions
3.4. Water Uptake
3.5. Fourier Transform Infrared Spectroscopy (FT-IR)
3.6. Scanning Electron Microscopy (SEM)
4. Conclusions
Acknowledgments
Author Contributions
Conflicts of Interest
References
- Fainleib, A.; Pires, R.V.; Lucas, E.F.; Soares, B.G. Degradation of non-vulcanized natural rubber–Renewable resource for fine chemicals used in polymer synthesis. Polim.-Cienc. Tecnol. 2013, 23, 441–451. [Google Scholar] [CrossRef]
- Riyajan, S.A.; Sangwan, W.; Leejarkpai, T. Synthesis and properties of a novel epoxidised natural rubber-g-cassava starch polymer and its use as an impact strengthening agent. Plast. Rubber Compos. 2016, 45, 277–285. [Google Scholar] [CrossRef]
- Ntumba, Y.H.T.; Prochon, M. The effect of modified keratin on the thermal properties of a cellulosic–elastomeric material. J. Therm. Anal. Calorim. 2016, 125, 1151–1160. [Google Scholar] [CrossRef]
- Prochon, M.; Ntumba, Y.H.T. The effect of modified biopolymers and poly(vinyl alcohol) on carboxylated acrylonitrile-butadiene rubber properties. Polimery 2015, 60, 508–515. [Google Scholar] [CrossRef]
- Prochon, M.; Ntumba, Y.H.T. Effects of biopolymer keratin waste sources in XNBR compounds. Rubber Chem. Technol. 2015, 88, 258–275. [Google Scholar] [CrossRef]
- Saboktakin, A.; Saboktakin, M. Improvements of physical, mechanical and biodegradation properties of polybutadiene rubber insulators by chitosan and silica nanoparticles. Int. J. Biol. Macromol. 2016, 91, 1194–1198. [Google Scholar] [CrossRef] [PubMed]
- Bogoeva-Gaceva, G.; Avella, M.; Malinconico, M.; Buzarovska, A.; Grozdanov, A.; Gentile, G.; Errico, M.E. Natural fiber eco-composites. Polym. Compos. 2007, 28, 98–107. [Google Scholar] [CrossRef]
- Mooney, B.P. The second green revolution? Production of plant-based biodegradable plastics. Biochem. J. 2009, 418, 219–232. [Google Scholar] [CrossRef] [PubMed]
- Manaila, E.; Craciun, G.; Stelescu, M.D.; Ighigeanu, D.; Ficai, M. Radiation vulcanization of natural rubber with polyfunctional monomers. Polym. Bull. 2014, 71, 57–82. [Google Scholar] [CrossRef]
- Stelescu, M.D.; Manaila, E.; Craciun, G.; Dumitrascu, M. New Green Polymeric Composites Based on Hemp and Natural Rubber Processed by Electron Beam Irradiation. Sci. World J. 2014, 2014, 684047. [Google Scholar] [CrossRef] [PubMed]
- Cristaldi, G.; Latteri, A.; Recca, G.; Cicala, G. Composites Based on Natural Fibre Fabrics. In Woven Fabric Engineering; Dubrovski, P.D., Ed.; Sciyo: Rijeka, Croatia, 2010; pp. 318–342. ISBN 978-953-307-194-7. Available online: www.intechopen.com (accessed on 5 April 2017).
- Begum, K.; Islam, M.A. Natural Fiber as a substitute to Synthetic Fiber in Polymer Composites: A Review. Res. J. Eng. Sci. 2013, 2, 46–53. [Google Scholar]
- Lopez-Mondejar, R.; Zuhlke, D.; Becher, D.; Riedel, K.; Baldrian, P. Cellulose and hemicellulose decomposition by forest soil bacteria proceeds by the action of structurally variable enzymatic systems. Sci. Rep. 2016, 6, 25279. [Google Scholar] [CrossRef] [PubMed]
- Gutarowska, B.; Michalski, A. Microbial Degradation of Woven Fabrics and Protection against Biodegradation. In Woven Fabrics; Jeon, H.Y., Ed.; Sciyo: Rijeka, Croatia, 2012; pp. 267–296. ISBN 978-953-51-0607-4. Available online: www.intechopen.com (accessed on 7 April 2017).
- Ravindran, R.; Jaiswal, A.K. Microbial Enzyme Production Using Lignocellulosic Food Industry Wastes as Feedstock: A Review. Bioengineering 2016, 3, 30. [Google Scholar] [CrossRef]
- Yasin, N.H.M.; Mumtaz, T.; Hassan, M.A.; Rahman, N.A. Food waste and food processing waste for biohydrogen production: A review. J. Environ. Manag. 2013, 130, 375–385. [Google Scholar] [CrossRef] [PubMed]
- Sahari, J.; Sapuan, S.M. Natural fibre reinforced biodegradable polymer composites. Rev. Adv. Mater. Sci. 2011, 30, 166–174. [Google Scholar]
- Hussain, A.I.; Abdel-Kader, A.H.; Ibrahim, A.A. Effect of Modified Linen Fiber Waste on Physico-Mechanical Properties of Polar and non-Polar Rubber. Nat. Sci. 2010, 8, 82–93. [Google Scholar]
- Esmaeili, A.; Pourbabaee, A.A.; Alikhani, H.A.; Shabani, F.; Esmaeili, E. Biodegradation of Low-Density Polyethylene (LDPE) by Mixed Culture of Lysinibacillus xylanilyticus and Aspergillus niger in Soil. PLoS ONE 2013, 8, e71720. [Google Scholar] [CrossRef] [PubMed]
- Gautam, R.; Bassi, A.S.; Yanful, E.K. A Review of Biodegradation of Synthetic Plastic and Foams. Appl. Biochem. Biotech. 2007, 141, 85–108. [Google Scholar] [CrossRef]
- Leja, K.; Lewandowicz, G. Polymer Biodegradation and Biodegradable Polymers—A Review. Pol. J. Environ. Stud. 2010, 19, 255–266. [Google Scholar]
- Abd-Ali, N.K. Deterioration the Properties of Contaminated Natural Rubber with Some Species of Microorganisms. Ind. Eng. Lett. 2014, 4, 23–29. [Google Scholar]
- Cherian, E.; Jayachandran, K. Microbial Degradation of Natural Rubber Latex by a novel Species of Bacillus sp. SBS25 isolated from Soil. Int. J. Environ. Res. 2009, 3, 599–604. [Google Scholar]
- Onyeagoro, G.N.; Ohaeri, E.G.; Timothy, U.J. Studies on Microbial Degradation of Natural Rubber Using Dilute Solution Viscosity Measurement and Weight Loss Techniques. Int. J. Basic Appl. Sci. 2012, 1, 448–460. [Google Scholar] [CrossRef]
- Chenal, J.M.; Chazeau, L.; Guy, L.; Bomal, Y.; Gauthier, C. Molecular weight between physical entanglements in natural rubber: A critical parameter during strain-induced crystallization. Polymer 2007, 48, 1042–1046. [Google Scholar] [CrossRef]
- Arroyo, M.; Lopez-Manchado, M.A.; Herrero, B. Organo-montmorillonite as substitute of carbon black in natural rubber compounds. Polymer 2003, 44, 2447–2453. [Google Scholar] [CrossRef]
- Kraus, G. Swelling of filler-reinforced vulcanizates. J. Appl. Polym. Sci. 1963, 7, 861–871. [Google Scholar] [CrossRef]
- Chirila, C.; Deselnicu, V.; Crudu, M. Comparative Study Egarding the Resistance of Wet-White and Wet-Blue Leather to The Growth of Fungi. Leather Footwear J. 2014, 14. [Google Scholar] [CrossRef]
- Kolybaba, M.; Tabil, L.G.; Panigrahi, S.; Crerar, W.J.; Powell, T.; Wang, B. Biodegradable Polymers: Past, Present, and Future. In Proceedings of the CSAE/ASAE Annual Intersectional Meeting, Fargo, ND, USA, 3–4 October 2003; p. RRV03-0007. Available online: https://pdfs.semanticscholar.org/0bd1/0fcec882f35f3443feebe7bbd401e8fc44d3.pdf (accessed on 5 April 2017).
- Shah, A.A.; Hasan, F.; Shah, Z.; Kanwal, N.; Zeb, S. Biodegradation of natural and synthetic rubbers: A review. Int. Biodeterior. Biodegrad. 2013, 83, 145–157. [Google Scholar] [CrossRef]
- Rose, K.; Steinbuchel, A. Biodegradation of Natural Rubber and Related Compounds: Recent Insights into a Hardly Understood Catabolic Capability of Microorganisms. Appl. Environ. Microbiol. 2005, 71, 2803–2812. [Google Scholar] [CrossRef] [PubMed]
- Pathak, V.M.; Navneet. Review on the current status of polymer degradation: A microbial approach. Bioresour. Bioprocess. 2017, 4, 1–31. [Google Scholar] [CrossRef]
- Mohan, D.; Pittman, C.U.; Steele, P.H. Pyrolysis of wood/biomass for bio-oil: A critical review. Energy Fuels 2006, 20, 848–889. [Google Scholar] [CrossRef]
- Manaila, E.; Stelescu, M.D.; Craciun, G.; Ighigeanu, D. Wood Sawdust/Natural Rubber Ecocomposites Cross-Linked by Electron Beam Irradiation. Materials 2016, 9, 503. [Google Scholar] [CrossRef]
- Yan, L.B.; Chouw, N.; Jayaraman, K. Flax fibre and its composites—A review. Compos. Part B Eng. 2014, 56, 296–317. [Google Scholar] [CrossRef]
- Dickenson, P.B. Natural rubber and its traditional use in underground pipe sealing rings. J. Rubber Res. Inst. Malaya 1969, 22, 165–175. [Google Scholar]
- Tsuchii, A.; Suzuki, T.; Takeda, K. Microbial Degradation of Natural Rubber Vulcanizates. Appl. Environ. Microbiol. 1985, 50, 965–970. [Google Scholar] [PubMed]
- Tsuchii, A.; Suzuki, T.; Fukuoka, S. Degradation of synthetic oligomers by microorganisms.5. Bacterial degradation of 1,4-type polybutadiene. Agric. Biol. Chem. 1984, 48, 621–625. [Google Scholar] [CrossRef]
- Tsuchii, A.; Suzuki, T.; Takahara, Y. Degradation of synthetic oligomers by microorganisms.3. Microbial degradation of cis-1-1,4-polyisoprene. Agric. Biol. Chem. 1979, 43, 2441–2446. [Google Scholar]
- Manaila, E.; Stelescu, M.D.; Craciun, G. Characteristics of Natural Rubber Blends Vulcanized with Electron Beam and Microwave. Leather Footwear J. 2011, 11, 43–52. [Google Scholar]
- Paul, A.; Joseph, K.; Thomas, S. Effect of surface treatments on the electrical properties of low-density polyethylene composites reinforced with short sisal fibers. Compos. Sci. Technol. 1997, 57, 67–79. [Google Scholar] [CrossRef]
- Joseph, K.; Thomas, S.; Pavithran, C. Effect of chemical treatment on the tensile properties of short sisal fibre-reinforced polyethylene composites. Polymer 1996, 37, 5139–5149. [Google Scholar] [CrossRef]
- Kumar, R.; Obrai, S.; Sharma, A. Chemical modifications of natural fiber for composite material. Chem. Sin. 2011, 2, 219–228. [Google Scholar]
- Mathew, L. Short Isora Fibre Reinforced Natural Rubber Composites. Ph.D. Thesis, Cochin University of Science and Technology, Kerala, India, 2006. [Google Scholar]
- Mohd Idrus, M.A.M.; Hamdan, S.; Rahman, M.R.; Islam, M.S. Treated Tropical Wood Sawdust-Polypropylene Polymer Composite: Mechanical and Morphological Study. J. Biomater. Nanobiotechnol. 2011, 2, 435–444. [Google Scholar] [CrossRef]
- Chaudhuri, S.; Chakraborty, R.; Bhattacharya, P. Optimization of biodegradation of natural fiber (Chorchorus capsularis): HDPE composite using response surface methodology. Iran. Polym. J. 2013, 22, 865–875. [Google Scholar] [CrossRef]
- Espert, A. Natural Fibres/Polypropylene Composites from Residual and Recycled Materials: Surface Modification of Cellulose Fibers, Properties and Environmental Degradation. Ph.D. Thesis, Department of Fibre and Polymer Technology, Royal Institute of Technology, Stockholm, Sweden, 2003. [Google Scholar]
- Linos, A.; Steinbüchel, A. Microbial Degradation of Natural and Synthetic Belonging to the Genus Gordona. Kautsch. Gummi Kunstst. 1998, 51, 496–499. [Google Scholar]
- Perez, J.; Munoz-Dorado, J.; de la Rubia, T.; Martinez, J. Biodegradation and biological treatments of cellulose, hemicellulose and lignin: An overview. Int. Microbiol. 2002, 5, 53–63. [Google Scholar] [CrossRef] [PubMed]
- Beguin, P.; Aubert, J.P. The biological degradation of cellulose. FEMS Microbiol. Rev. 1994, 13, 25–58. [Google Scholar] [CrossRef] [PubMed]
- Leschine, S.B. Cellulose degradation in anaerobic environments. Annu. Rev. Microbiol. 1995, 49, 399–426. [Google Scholar] [CrossRef] [PubMed]
- David, A.; Medvedovici, A. Metode de Separare si Analizã Cromatograficã, 2nd ed.; Universitãþii din Bucureoti: Bucharest, Romania, 2008; pp. 32–36. [Google Scholar]
- Ali, A.M.M.; Subban, R.H.Y.; Bahron, H.; Winie, T.; Latif, F.; Yahya, M.Z.A. Grafted natural rubber based polymer electrolytes: ATR-FTIR and conductivity studies. Ionics 2008, 14, 491–500. [Google Scholar] [CrossRef]
- Afiq, M.M.; Azura, A.R. Effect of sago starch loadings on soil decomposition of natural rubber latex (NRL) composite films mechanical properties. Int. Biodeterior. Biodegrad. 2013, 85, 139–149. [Google Scholar] [CrossRef]
- Coates, J. Interpretation of Infrared Spectra, a Practical Approach. In Encyclopedia of Analytical Chemistry, 1st ed.; Meyers, R.A., Ed.; John Wiley & Sons Ltd.: Chichester, UK, 2000; pp. 10815–10837. Available online: https://pdfs.semanticscholar.org/9203/59b562f615d9f68f8e57b6b6b505aa213174.pdf (accessed on 15 June 2017).
- Renouard, S.; Hano, C.; Ouagne, P.; Blondeau, J.P.; Laine, E. Protection of flax fiber-based yarns against natural soil degradation by chitosan. Mater. Lett. 2014, 137, 269–273. [Google Scholar] [CrossRef]
- Buranov, A.U.; Mazza, G. Lignin in straw of herbaceous crops. Ind. Crop. Prod. 2008, 28, 237–259. [Google Scholar] [CrossRef]
- Liang, C.Y.; Marchessault, R.H. Infrared spectra of crystalline polysaccharides. I. Hydrogen bonds in native celluloses. J. Polym. Sci. Polym. Chem. 1959, 37, 385–395. [Google Scholar] [CrossRef]
- Waldrop, M.P.; Balser, T.C.; Firestone, M.K. Linking microbial community composition to function in a tropical soil. Soil Biol. Biochem. 2000, 32, 1837–1846. [Google Scholar] [CrossRef]
- Hulleman, S.H.D.; Van Hazendonk, J.M.; Vandam, J.E.J. Determination of crystallinity in native cellulose from higher plants with diffuse reflectance Fourier transform infrared spectroscopy. Carbohydr. Res. 1994, 261, 163–172. [Google Scholar] [CrossRef]
- Verran, J.; Rowe, D.L.; Cole, D.; Boyd, R.D. The use of the atomic force microscope to visualise and measure wear of food contact surfaces. Int. Biodeterior. Biodegrad. 2000, 46, 99–105. [Google Scholar] [CrossRef]
- Jenings, D.H.; Lysek, G. Fungal Biology: Understanding the Fungal Lifestyle, 2nd ed.; Bios Scientific Publisher Ltd.: Oxford, UK, 1999; pp. 63–65. [Google Scholar]
- Zeb, S. Vulcanized Rubber Degrading Paecilomyces variotii Strain SFA-25 Isolated from Hot Spring in Pakistan. Master’s Thesis, Quaid-i-Azam University, Islamabad, Pakistan, 2009. [Google Scholar]

| Samples Codes | Amount of Materials (phr) | |||||
|---|---|---|---|---|---|---|
| Natural Rubber | PEG 4000 | Irganox 1010 | Perkadox 14-4B | Flax Fibers | Wood Sawdust | |
| A | 100 | 3 | 1 | 8 | - | - |
| B-1 | 100 | 3 | 1 | 8 | 10 | - |
| B-2 | 100 | 3 | 1 | 8 | 20 | - |
| C-1 | 100 | 3 | 1 | 8 | - | 10 |
| C-2 | 100 | 3 | 1 | 8 | - | 20 |
© 2017 by the authors. Licensee MDPI, Basel, Switzerland. This article is an open access article distributed under the terms and conditions of the Creative Commons Attribution (CC BY) license (http://creativecommons.org/licenses/by/4.0/).
Share and Cite
Stelescu, M.-D.; Manaila, E.; Craciun, G.; Chirila, C. Development and Characterization of Polymer Eco-Composites Based on Natural Rubber Reinforced with Natural Fibers. Materials 2017, 10, 787. https://doi.org/10.3390/ma10070787
Stelescu M-D, Manaila E, Craciun G, Chirila C. Development and Characterization of Polymer Eco-Composites Based on Natural Rubber Reinforced with Natural Fibers. Materials. 2017; 10(7):787. https://doi.org/10.3390/ma10070787
Chicago/Turabian StyleStelescu, Maria-Daniela, Elena Manaila, Gabriela Craciun, and Corina Chirila. 2017. "Development and Characterization of Polymer Eco-Composites Based on Natural Rubber Reinforced with Natural Fibers" Materials 10, no. 7: 787. https://doi.org/10.3390/ma10070787
APA StyleStelescu, M.-D., Manaila, E., Craciun, G., & Chirila, C. (2017). Development and Characterization of Polymer Eco-Composites Based on Natural Rubber Reinforced with Natural Fibers. Materials, 10(7), 787. https://doi.org/10.3390/ma10070787
